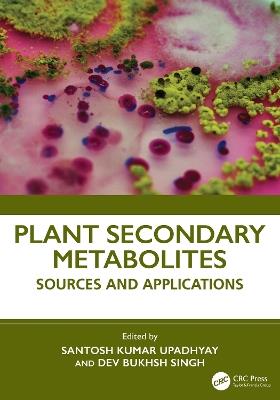
Plant Secondary Metabolites: Sources and Applications - cover

L’articolo è stato aggiunto alla lista dei desideri
IBS.it, l'altro eCommerce
Plant Secondary Metabolites: Sources and Applications
Cliccando su “Conferma” dichiari che il contenuto da te inserito è conforme alle Condizioni Generali d’Uso del Sito ed alle Linee Guida sui Contenuti Vietati. Puoi rileggere e modificare e successivamente confermare il tuo contenuto. Tra poche ore lo troverai online (in caso contrario verifica la conformità del contenuto alle policy del Sito).
Grazie per la tua recensione!
Tra poche ore la vedrai online (in caso contrario verifica la conformità del testo alle nostre linee guida). Dopo la pubblicazione per te +4 punti
Altre offerte vendute e spedite dai nostri venditori



Tutti i formati ed edizioni
Promo attive (0)
This book explores the pharmacological potentials of various classes of plant secondary metabolites. The initial chapter introduces the chemical diversity, biosynthesis pathways, and ecological functions of plant secondary metabolites. It discusses the pivotal role of transcription factors in regulating their production. Furthermore, the book examines the specific classes of secondary metabolites, such as phenolic compounds, terpenes, and anthocyanins, highlighting their properties and various applications across the food, cosmetics, and pharmaceutical industries. This book delves into emerging areas such as plant metabolites as nutraceuticals, the utilization of horticultural and vegetable crops for secondary metabolite production, and the exploration of staple crops for health improvements. The chapters discuss the applications of fungal endosymbionts and algal sources in shaping plant metabolite compositions. The chapters further review innovative techniques, such as hairy root engineering and recombinant systems, for enhancing metabolite production. The book concludes with a detailed overview of methods for isolating and identifying secondary metabolites. This book is an essential resource for students, researchers, and professionals of ethnopharmacology, pharmaceutical sciences, botany, and biomedical sciences. Key Features: Covers various classes of plant secondary metabolites and their pharmacological potentials Explores the role of transcription factors in controlling secondary metabolite production in plants Discusses secondary metabolites from horticultural and vegetable crops, highlighting their pharmaceutical applications Presents techniques like hairy root engineering and recombinant systems for enhancing metabolite production Examines lichen metabolites and their applications in human health, as well as metabolites from gymnosperms
L'articolo è stato aggiunto al carrello
Le schede prodotto sono aggiornate in conformità al Regolamento UE 988/2023. Laddove ci fossero taluni dati non disponibili per ragioni indipendenti da IBS, vi informiamo che stiamo compiendo ogni ragionevole sforzo per inserirli. Vi invitiamo a controllare periodicamente il sito www.ibs.it per eventuali novità e aggiornamenti.
Per le vendite di prodotti da terze parti, ciascun venditore si assume la piena e diretta responsabilità per la commercializzazione del prodotto e per la sua conformità al Regolamento UE 988/2023, nonché alle normative nazionali ed europee vigenti.
Per informazioni sulla sicurezza dei prodotti, contattare productsafetyibs@feltrinelli.it
L’articolo è stato aggiunto alla lista dei desideri